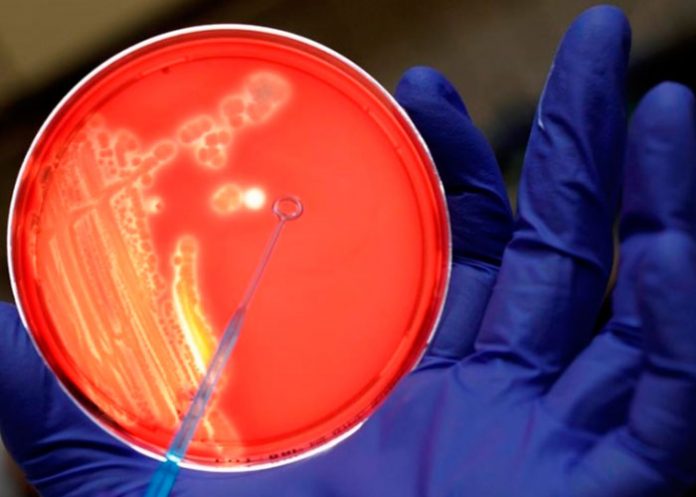

Barcelona (España), 6 dic (EFE).- Un estudio liderado por investigadores españoles concluye que el proceso mediante el cual las células son capaces de percibir su entorno está regulado por la detección de fuerzas y que la precisión que alcanzan con este tanteo es "nanométrica".
El estudio, publicado en la revista Nature, está liderado por el equipo de Pere Roca-Cusachs, investigador principal del Instituto de Bioingeniería de Cataluña (IBEC) y profesor de la Universidad de Barcelona.
Pere Roca-Cusachs ha comparado este proceso con el de "reconocer la cara de alguien a oscuras resiguiéndola con una mano, más que viendo a la persona".
"Al adherirse a sus ligandos (usualmente moléculas), las células aplican una fuerza que pueden detectar. Como esta fuerza depende de la distribución espacial de los ligandos, esto permite a las células tantean su entorno", explica el investigador en un comunicado.
Un ligando es una sustancia (usualmente una molécula pequeña) que forma un complejo con una biomolécula.
Hasta ahora se sabía que las células son capaces de percibir información espacial y física a nanoescala y se creía que eran capaces de "medir distancias" y por eso se había conjeturado con la existencia de algún tipo de molécula patrón que las ayudara en este proceso.
Este trabajo "contradice" esta hipótesis, afirma el investigador del IBEC-UB, demostrando que las células "tantean" más que "ven" su entorno.
La interacción entre las células y sus ligandos o microentorno celular es esencial para mantener la función de cualquier tejido, y de hecho la detección de cambios en el entorno celular es fundamental en cualquier escenario donde haya una remodelación de tejido, como puede ser el desarrollo embrionario, la proliferación tumoral o el proceso con el cual se cierra una herida.
En el trabajo también se ha visto cómo, "en función de esta distribución de fuerzas de la célula, se incide en la activación de la transcripción genética, fenómeno que determina qué genes se expresan", apunta Roger Oria, primer autor del estudio y estudiante de doctorado en el laboratorio del doctor Roca-Cusachs.
Con este conocimiento más integrado de cómo la célula detecta su entorno, los investigadores del IBEC han comprobado que modificando las condiciones del entorno de la célula -rigidez y distribución de los ligandos que forman la matriz extracelular- se puede controlar la respuesta de adherencia de la célula e, incluso, definir un rango en el cual la célula se adhiere y fuera del cual no lo hace.
Este resultado, apunta Roca-Cusachs, puede ser especialmente relevante en procesos tumorales, dado que está bastante aceptado que una mayor rigidez está relacionada con una mayor activación de los oncogenes.
Para llevar a cabo el trabajo, los investigadores han desarrollado unos sustratos de geles blandos en los que se incorpora un patrón de nanoesferas de oro recubiertas de una proteína, pudiendo controlar su separación.
La célula reconoce estas nanoesferas como un ligando y por lo tanto se puede medir de qué manera las células modulan la distribución de fuerzas y el número de ligandos a los cuales se adhieren en función de la densidad.
En este estudio han colaborado, entre otros, el Instituto de Investigación en Ingeniería de Aragón de la Universidad de Zaragoza (España), el Instituto Max Planck y la Universidad Heidelberg en Alemania.
Este trabajo ha sido financiado por la Comisión Europea, el Ministerio de Economía y Competitividad de España, el Consejo Europeo de Investigación, la Fundación Bancaria "la Caixa", la Fundación la Marató de TV3 y la Fundación Alemana de Ciencias.